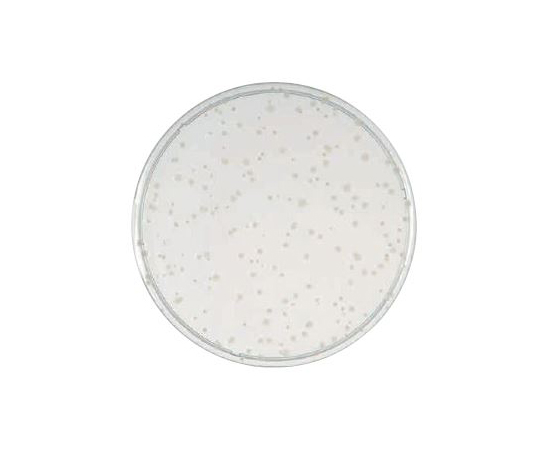
63-6526-73 BD BBL（TM） YSG寒天培地 1個（1本×20枚入） 252029

ちびすけ Clair】ちびすけ🚬🐰 (@Kiiro_NB0104) / Posts / X
(3002件)
Pontaパス特典
サンキュー配送
45314円(税込)
454ポイント(1%)
Pontaパス会員ならさらに+1%ポイント還元!
送料
(
)
3002
配送情報
お届け予定日:2026.04.22 23:47までにお届け
※一部地域・離島につきましては、表示のお届け予定日期間内にお届けできない場合があります。
ロットナンバー
73136252029
お買い物の前にチェック!

Pontaパス会員なら
ポイント+1%
ポイント+1%
商品説明





海外製品の為ご理解のある方のみ購入して下さい自宅保管の為神経質な方はご遠慮下さいおまとめの対応、割引等なんでもお気軽にコメント下さい購入後の対応は厳しい為購入前の確認はコメントにてして頂きますようにお願いします。
| カテゴリー: | ゲーム・おもちゃ・グッズ>>>K-POP>>>メモ用紙・文房具 |
|---|---|
| 商品の状態: | 新品、未使用","新品で購入し、一度も使用していない |
| 配送料の負担: | 送料込み(出品者負担) |
| 配送の方法: | 佐川急便/日本郵便 |
| 発送元の地域: | 未定 |
| 発送までの日数: | 2~3日で発送 |
レビュー
商品の評価:




 4.5点(3002件)
4.5点(3002件)
- aisya1018
- 習い始めた娘の為に購入しました。 これから練習しようと思います。 ビックリする位早く届きました。
- tiro 125
- シークレットトークが聞きたくて持っていないCDすべてをまとめ購入です
- キムヒロ6032
- シークレットトークが聞きたくて持っていないCDすべてをまとめ購入です
- ぶーちゃん丸7869
- シークレットトークが聞きたくて持っていないCDすべてをまとめ購入です
- Show_show_Show
- 3880円もした。正規の値段だと思い買ったら1470円のもの。正直、ぼったくられた気分。発送も遅く2度と買わない。差額を返してほしい。最低な店。
- ochano
- 山Pいいですね★ DVDも素敵でした★ 得点にポスターついてて更にテンションあがりました★
- ninja636
- シングル以外の曲も結構良かったです。 元気が出る曲が多いので、うちの主人は筋トレする時にかけています。 蜷川実花さん撮影のミニ写真集も色がとても鮮やかでキレイでした。
- シーちゃん2081
- ショップの対応もよく、オマケに何が来るかいつもワクワクしてしまいます(^^)
- youyou1661
- 初めて中古で初回限定盤を購入しました。中古でしか手に入らないので。 CDとDVDともにキレイで、お値段ほぼ定価と一緒。 クリップ集も持っているのですが、truthだけのDVDが欲しかった!! 満足です。エンドレスで見続けると思います。
- ena555536
- 4日に支払い13日に届きました☆ いつ届くか連絡したのですが ちゃんと返信してくださったので 対応が良いショップ様です☆ 中身ですが、、 BのMVはダンスなんですが フォーメーションが良い☆ 関係無いけどyoutubeに投稿してる著作権無視な残念なファンがいるのは残念ですが ファンならマナーを守って欲しいです やっぱモー娘がアイドルで一番です(^o^)/☆ ☆りょうこ
- j0140411_41
- 握手券はとても人気でお店に行ってもなかなか予約が出来ないので、値段は高かったですが、確実に手に入るので購入して良かったです。 商品も新品でとても綺麗でした。
- シィナナ
- よかったです。コンサートにはあたりませんでしたが・・
すべて見る
お店の情報
7,367
連絡・応対
4.3
配送スピード
4.3
梱包
4.3